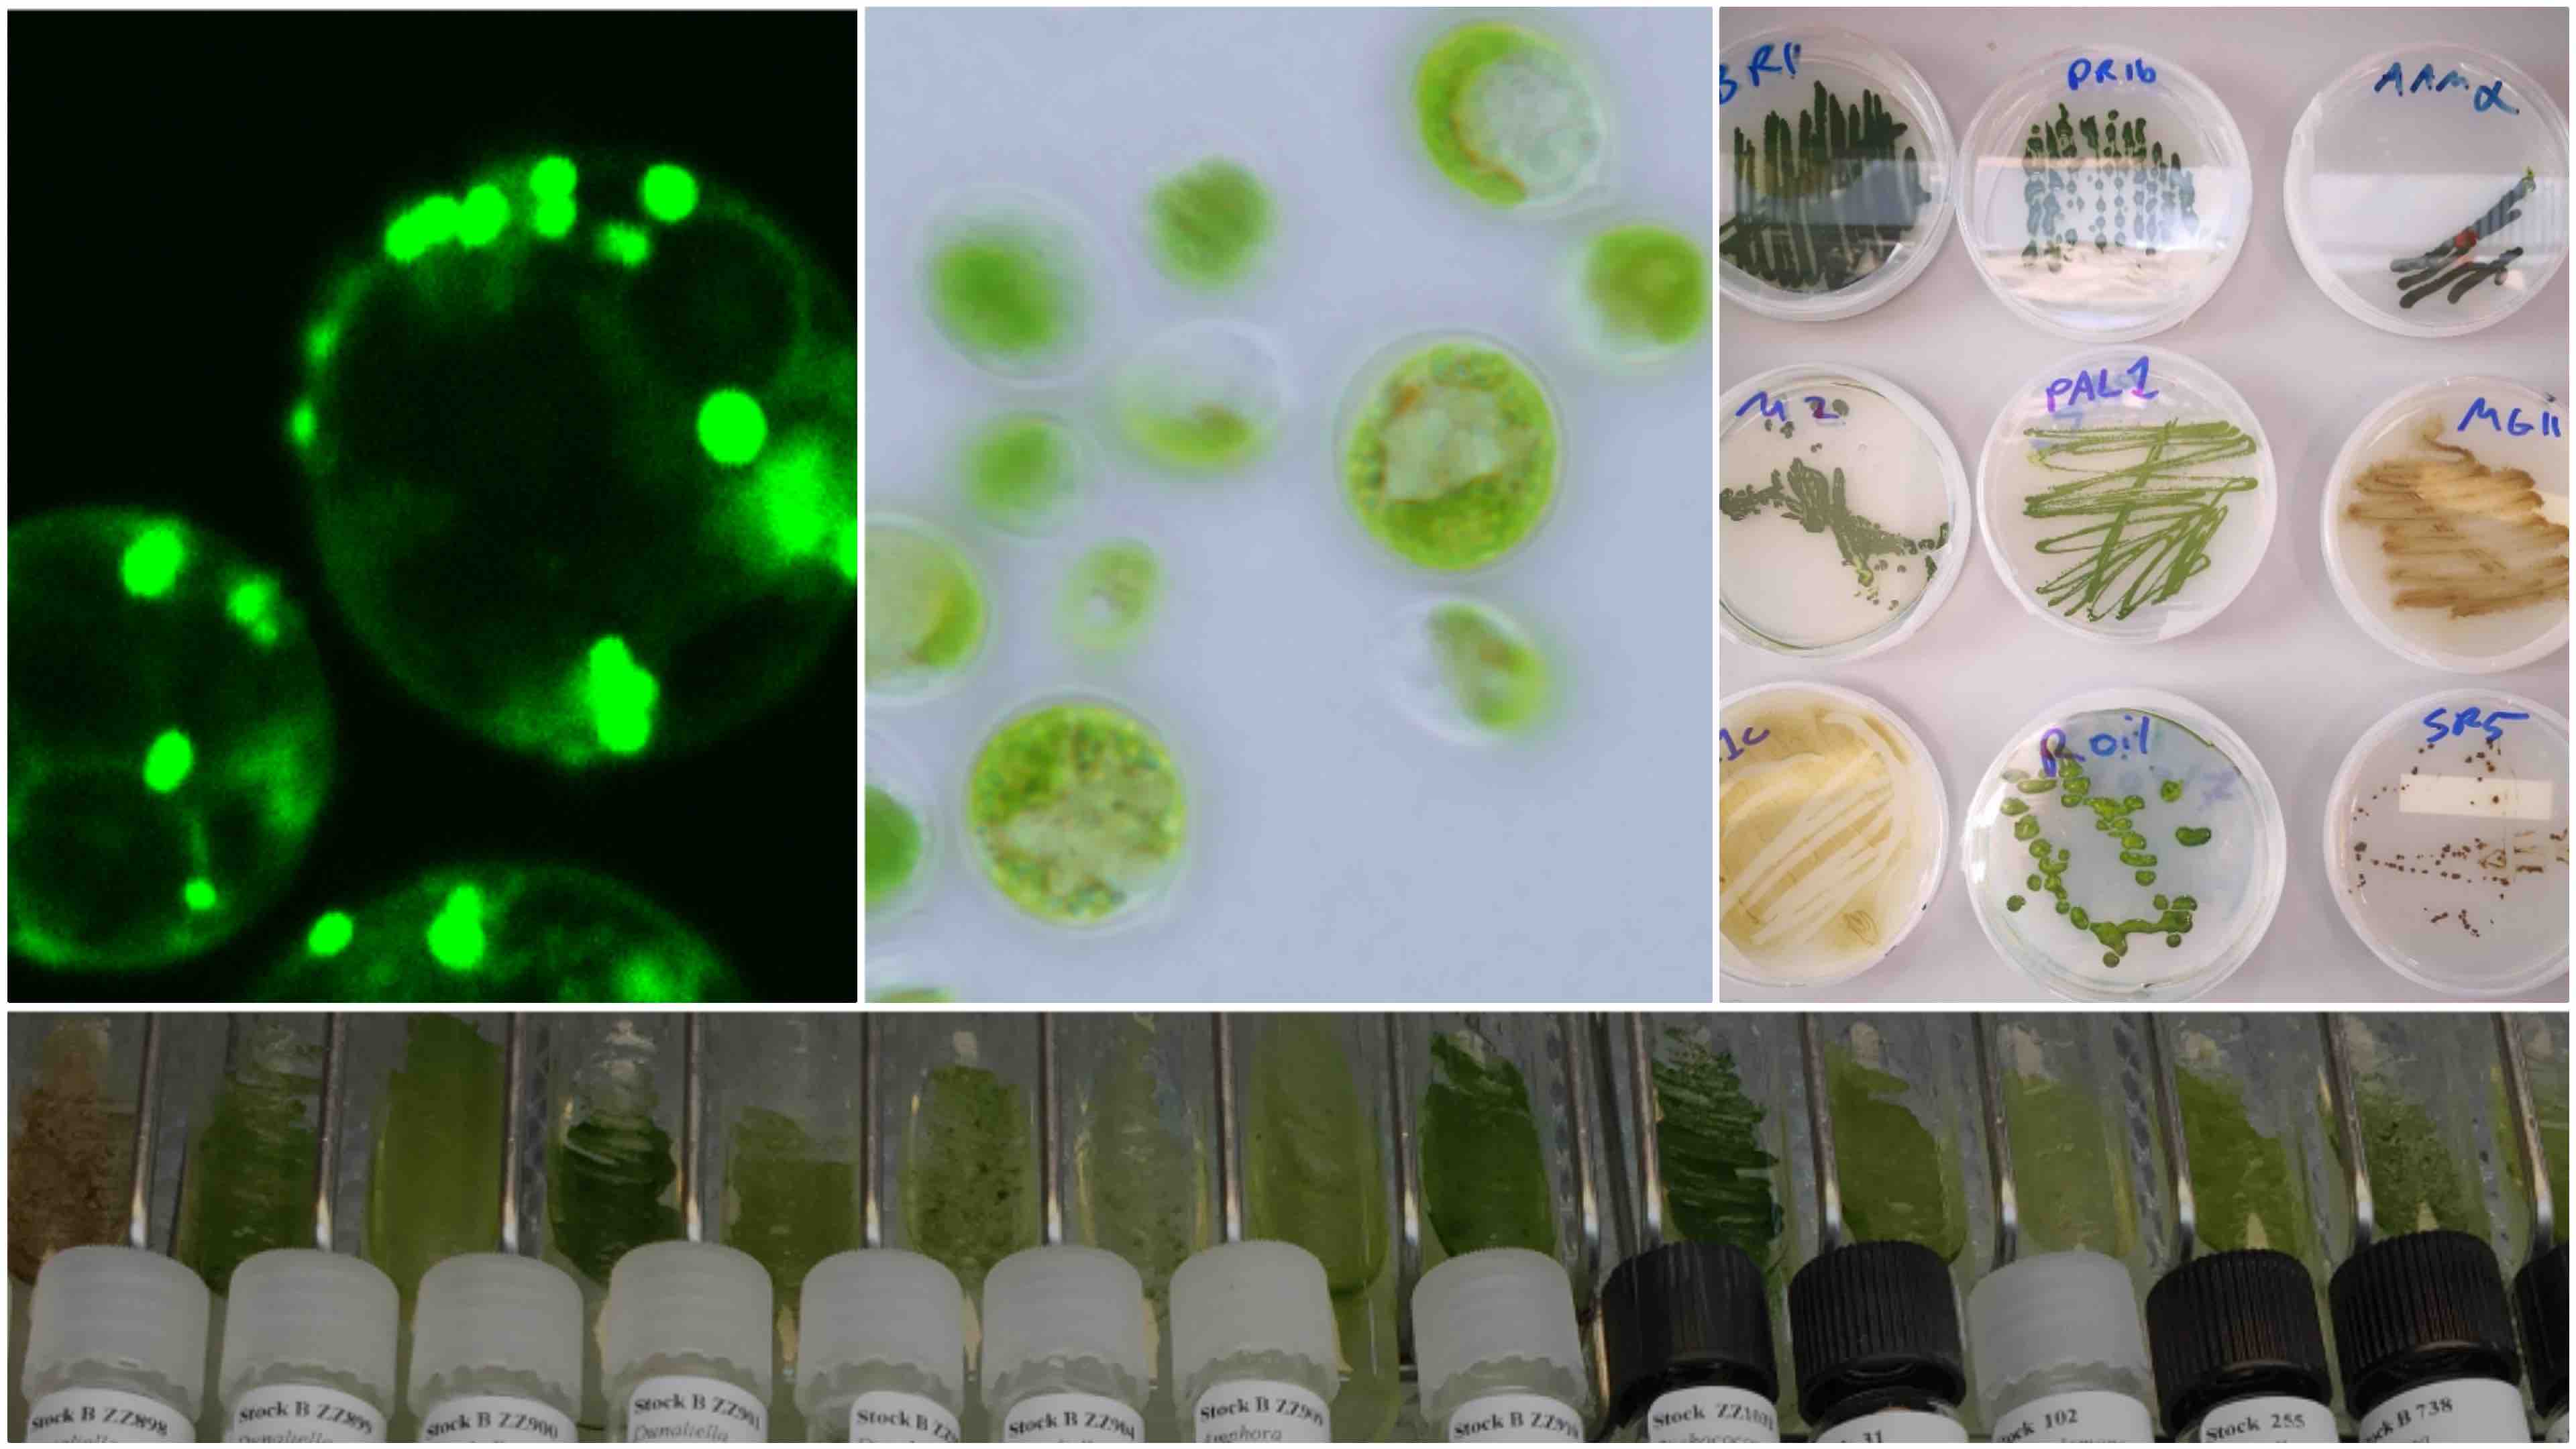
Breakthrough AI From NYUAD Speeds Up Discovery of Life-Supporting Microbes

Science
The Division of Science at NYU Abu Dhabi drives discovery through cutting-edge research that spans the physical, biological, computational, and psychological sciences. Faculty and researchers investigate fundamental questions about the universe and life itself while translating their findings into innovations that advance health, sustainability, and technology. Through collaboration across disciplines and partnerships worldwide, the Division contributes to scientific progress with global impact and prepares students to become leaders in research and discovery.
Latest News
Research Spotlight
The Algorithm Architect
When you unlock your phone, follow a map, or rely on a smart device to make a decision, there is an invisible layer of mathematics guiding every step. That hidden machinery is where Associate Professor of Computer Science Saurabh Ray does his most important work.
Making Complex Science Accessible
Renowned Oxford researcher and educator joins NYU Abu Dhabi as visiting professor, eager to inspire students and forge new scientific collaborations in the UAE.
Advancing Organic Synthesis Through a Global PhD Fellowship
With a foundation in organic synthesis, Global PhD Fellow Thowfik Salam joins NYUAD to advance research at the intersection of chemistry, innovation, and interdisciplinary collaboration.